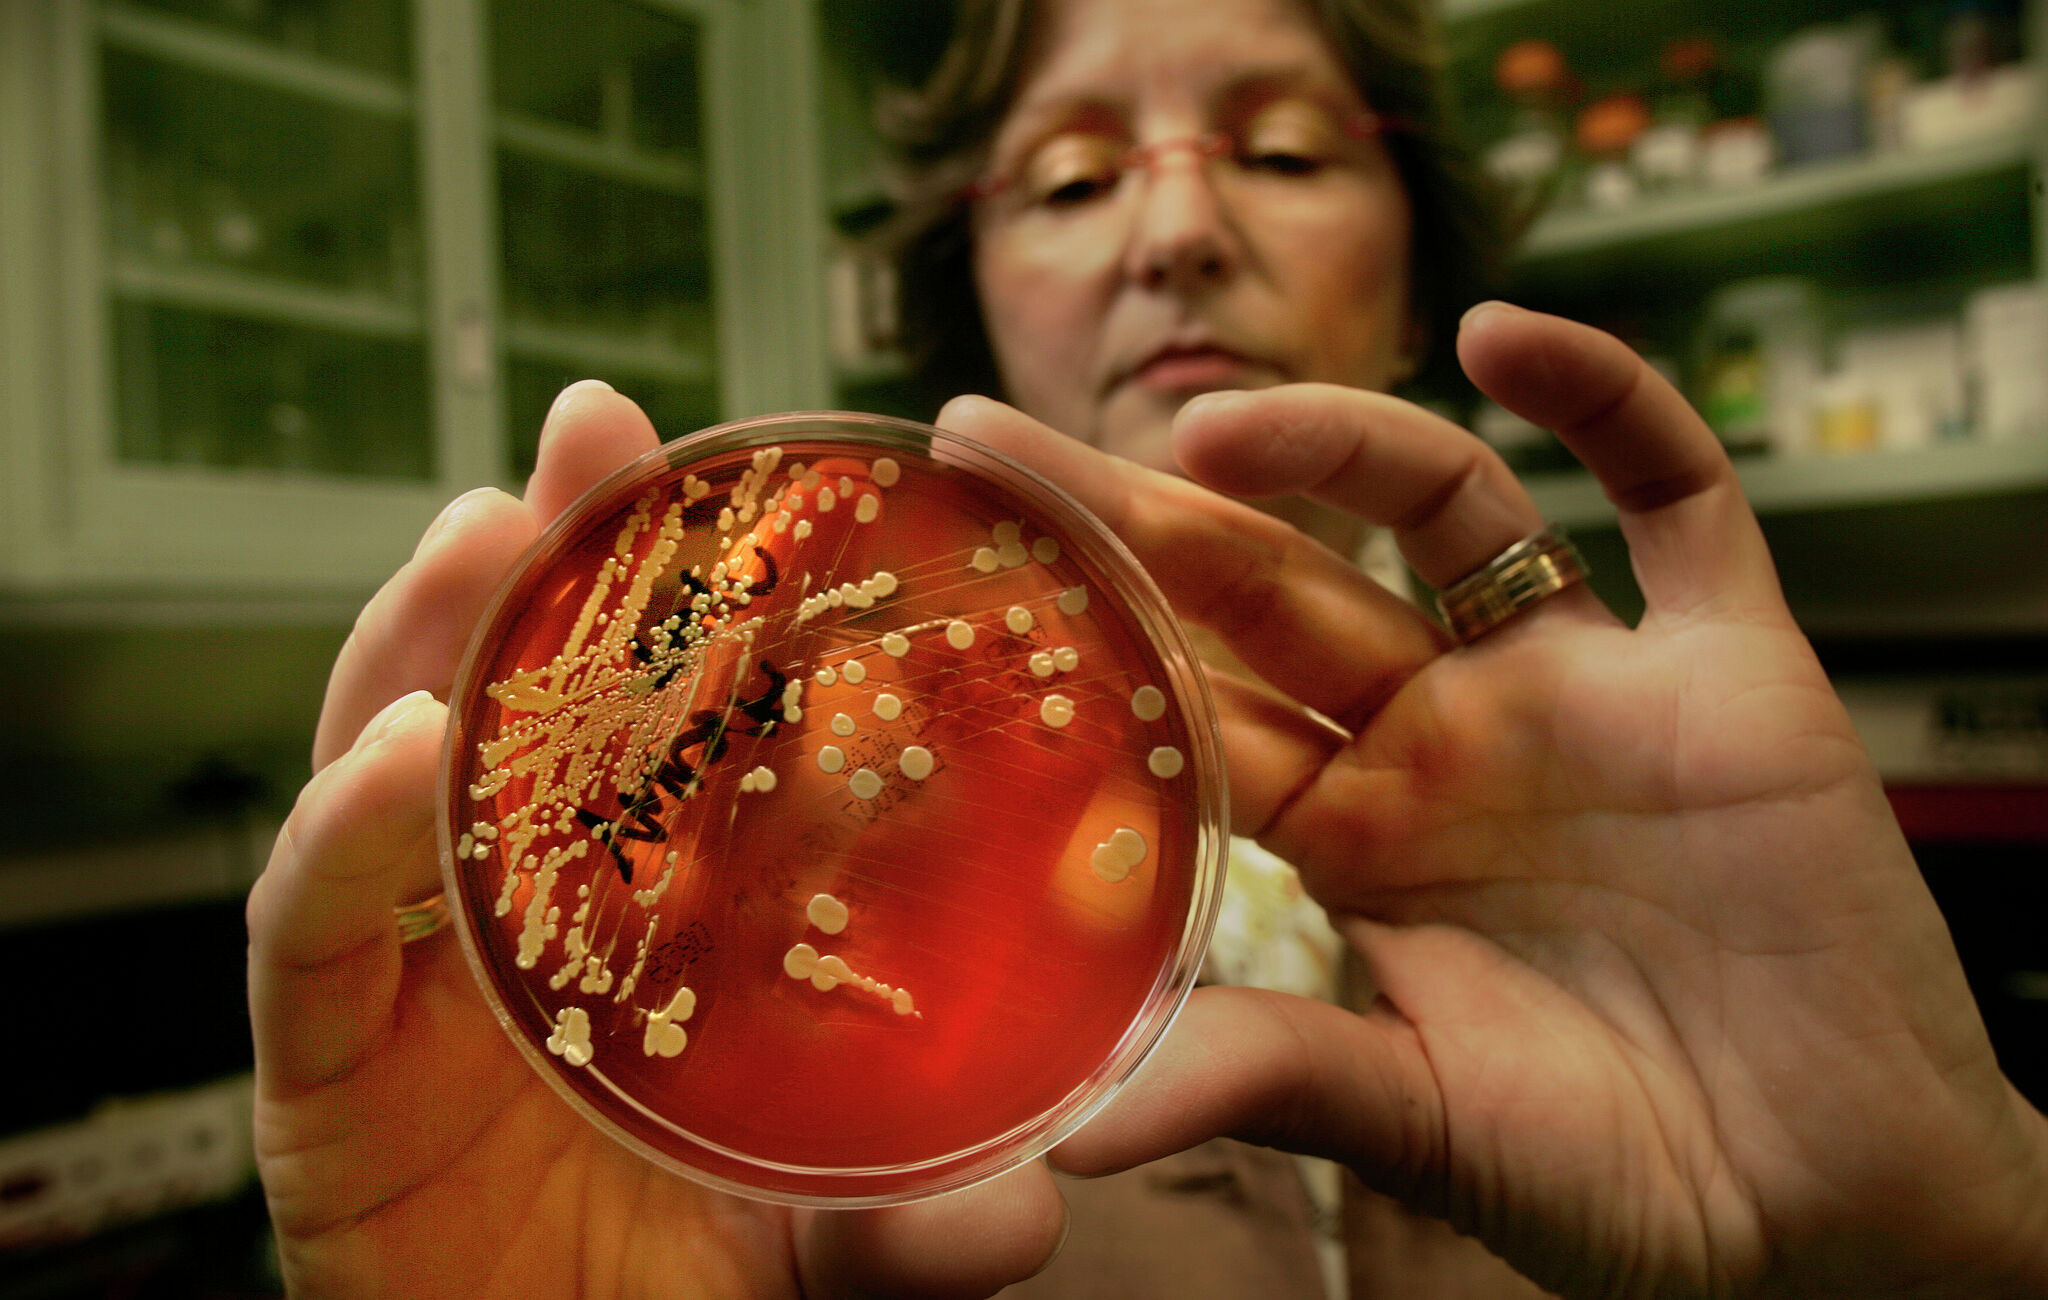
https://s.hdnux.com/photos/01/55/36/61/28699740/3/rawImage.jpg

Trinity Rodman contract saga timeline: NWSL board making moves to keep superstar?
- Posted on December 11, 2025
- By CBS Sports
- 1 Views

Trinity Rodman contract saga timeline: NWSL board making moves to keep superstar?

Where Rodman plays next is anyone's guess, but her drawn-out contract saga has featured some interesting events